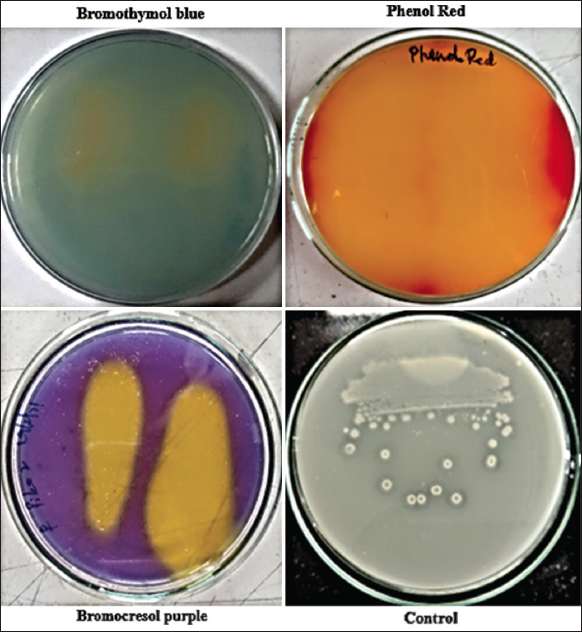

1. INTRODUCTION
Silica is a key element of soil playing an important role in the growth of plants by providing resistance to abiotic and biotic stress which occupies 27% of earth’s crust [1]. Initially, silica was not considered as a plant essential element, but the beneficial effects of silica on the plants made the Association of American Plant Food Control officials to consider it as “beneficial element” [2]. Silica was also considered as a “quasi – essential element” as the deficiency may leads to disorders in plants [3].
Silica has proven plant benefits in enhancing the growth and development of various crops by strengthening the cell walls and also by inducing systemic acquired resistance towards various plant pathogens [4]. Deposition of silica in the plant cell walls avoids the formation of appressorium by the plant fungal pathogens. Silica has proven benefits in plants enhancing the photosynthetic rate, inducing drought mitigation, enhancing the survivability in alkaline soils, saline soils, and metal toxicity soils [5].
Silica is in insoluble form in the soil as Mg, Al, Fe, Na, K, or Ca silicates (SiO3) [1,2]. The unavailable silica forms are converted into soluble mono silicic acid, which is the plant’s preferred form for uptake, by the biological or chemical process. Silicate solubilizing microbes play a crucial role in the solubilization of silicates [3,6,7].
Organic acids secreted by the microbes will dissolve the insoluble form of phosphates or silicates and convert them into a plant-available soluble form [8]. Some important genera possessing silicate solubilization efficiency are Bacillus spp., Enterobacter spp., Burkholderia spp., Pseudomonas spp., and Rhizobium spp. [1]. Although several silicate solubilizing microbes were notified, Bacillus spp. has made its mark by their remarkable endospore forming ability, enabling to survive in harsh unfavorable conditions [3,9].
Based on the silicon assimilation, the plants are segregated into 3 types’, namely, accumulators, intermediates, and excluders. Plant accumulators such as Zea mays L., Oryza sativa L., and Saccharum officinarum L. accumulate high content of biogenic silica in their plant parts [10].
Although various benefits of silica deposition in plants were noticed, isolating and screening potential silicate solubilizing bacteria is challenging. Harnessing the silicate solubilization efficiency on the conventional media with magnesium trisilicate makes observation more challenging as the color of the media is off-white with translucent silicate solubilization zones [1,11]. Various microbial isolates solubilize silica by secretion of organic acids, which can be easily detected by adding an acid base dye in the medium for proper visualization.
The current study emphasizes in isolating and screening a silicate solubilizing bacterium which can be used as an agricultural microbial inoculant. Conventional Bunt and Rovira media were modified using acid base indicator dye for making the screening process much easier [12]. Silicate solubilizing bacteria obtained was characterized by morphological and molecular techniques. Key secondary metabolites responsible for silicate solubilization and other plant growth promoting characters were also studied.
2. MATERIALS AND METHODS
2.1. Soil Samples Collection
Soil samples from the rhizosphere zone were collected from the Bowrampet village (17.5749°N, 78.3910°E), Telangana, India, where maize had been under continuous cultivation for the last decade. Maize rhizosphere soils were collected from a depth of 10 cm in a sterile gamma irradiated container. Rhizosphere soil sample (10 g) was taken in 250 mL Erlenmeyer flask, 90 mL of 0.85% NaCl solution was added and kept on an orbital shaker at 120 rpm for 30 min. Serial dilution of the rhizosphere soil was carried till 10-7 and 0.1 mL of the aliquot was inoculated into Luria Bertani agar plates (HiMedia M1151) and incubated at 30°C for 48 h. Bacterial colonies were isolated, subcultured, and stored in Luria Bertani agar slants at 4°C [5,13].
2.2. Developing a Modified Plate Assay
A modified plate assay for the isolation of silicate solubilizing bacteria was developed by incorporating the acid base indicator dyes into the selective media with the following composition glucose 10 g/L, magnesium trisilicate 2.5 g/L and agar 20 g/L [11,14]. Observation of bacterial colonies and silicate solubilization zones formed on the conventional Bunt and Rovira media was challenging as the color of the medium was off-white. To address the issue, various acid base indicator dyes, that is, 0.0025% bromocresol purple, 2 mL of (0.002 g in 0.5% alcoholic solution) bromothymol blue and 0.1 g/L of phenol red were added in different medium sets. Different acid base dyes were used in order to screen the suitable dye for Bunt and Rovira medium which also makes the screening process easier [1,12,15].
Bacterial isolates were screened for their silicate solubilization efficiency using the modified selective media. Microbial isolates were inoculated on the modified agar plates and incubated for 24–168 h (7 days) at 30°C. Bacterial isolates showing a high zone of silicate solubilization were screened and the isolate showing a high silicate solubilization zone was further studied [2,6].
2.3. Quantification of Silicate Solubilization
Quantification of silicate dissolution was done using the standard spectrophotometric assay which includes inoculation of a loopful of culture into the selective liquid medium with composition glucose 10 g/L and magnesium trisilicate 2.5 g/L with pH 7.0. After 5 days of incubation, the microbial broth was centrifuged (REMI R4C) and the top supernatant layer was collected. Boric acid 2.5% was added to the supernatant in the ratio 3:1 followed by the addition of 5.4% ammonium molybdate (1:1). After incubating the mixture for 5 min, 20% of tartaric acid and ascorbic acid (0.5%) were added to 1 mL of total volume. The reaction mixture was vortexed (REMI CM101) and absorbance was recorded at 650 nm by using a UV-visible spectrophotometer (Elico SL 244) [16]. Silicon dioxide (1 g) was heated in muffle furnace at 500°C for 2 h. Sodium carbonate (0.2 g) was added to 0.1 g of silicon dioxide and heated at 500°C in muffle furnace for 2 h. The mixture was dissolved in boiled double distilled water and the volume was made to 1 L. Different concentrations of stock solution were transferred (0–10 mL) in respective tubes and the volume was made to 10 mL using distilled water. Absorbance values were measured at 650 nm and the standard graph was constructed [14].
2.4. Characterization of Organic Acids
The supernatant from bacterial culture was analyzed using gas chromatography–mass spectrometry (GC-MS) (Perkin Elmer Clarus 680). Supernatant was filtered using Whatman no. 1 filter, filtrate was mixed in the ethanol in the ratio 1:1 and vortexed for 1 min. A sample quantity of 1 μL was injected into the GC-MS containing a fused silica column, with Elite – 5 MS (30 m × 0.25 mm ID × 250 μm df, 5% biphenyl 95% dimethyl polysiloxane). Helium was the carrier and maintained at a constant flow rate of 1 mL/min. The injector temperature was maintained at 260°C and the sample was injected at an oven temperature of 60°C for 2 min. The mass detector’s transfer line and ion source temperatures were maintained at 230°C with an electron impact of 70 eV and scanned. Compounds were identified by NIST library comparative search [17].
2.5. Qualitative and Quantitative Estimation of Indole Acetic Acid (IAA)
Qualitative estimation of IAA was done using the Salkowski reagent which was prepared with 50 mL of 35% perchloric acid and 1 mL of 0.5 M Ferric chloride. The bacterial culture was inoculated into the LB broth (tryptone 10 g/L, yeast extract 5 g/L, NaCl 10 g/L, and pH 7.0) and incubated for 24 h at 120 rpm. Bacterial broth was centrifuged (REMI R4C) at 10,000 rpm for 10 min and the top supernatant layer was collected. Salkowski reagent (0.5 mL) was added to the supernatant and incubated in dark for 30 min. A change in the color intensity to pink color was observed, indicating the presence of IAA [2].
Quantitative estimation of IAA secreted by the microbial isolate was done by UV spectrophotometer (Elico SL 244) using the Salkowski reagent. Bacterial isolate was inoculated into a sterilized Luria Bertani medium and incubated at 37°C for 24 h on an orbital shaker at 120 rpm. The bacterial culture broth was centrifuged for 25 min at 5000 rpm and the supernatant portion was collected. The supernatant was mixed with the Salkowski reagent in the ratio of 2:1 and the absorbance was recorded at 530 nm. Standard graph was constructed by taking different IAA concentrations (0, 1, 2, 3, 4, 5, 6, 7, and 8 μg/mL) to which 0.5 mL of Salkowski reagent was added and the total volume was made to 10 mL using distilled water. Absorbance values were recorded at 530 nm and the standard graph was plotted [18].
2.6. Antagonistic Activity
Freshly grown silicate solubilizing bacteria (0.1 mL) with 1.0 × 109 CFU/mL were poured and spread on the potato dextrose agar plates. A week old, Fusarium oxysporum culture was taken by using the cork borer, 5 mm block was cut. The block was placed on the potato dextrose agar plate having bacterial culture. The percentage of mycelial suppression was calculated using a formula. The percentage of mycelial inhibition (%) = Mycelial growth in control – Mycelial growth in treated/Mycelial growth in control [19].
2.7. Morphological and Molecular Identification of Silicate Solubilizing Bacteria
Silicate solubilizing bacterial isolate was morphologically characterized using the scanning electron microscope. Bacterial culture was smeared on the coverslip and carbon-coated for better visualization. The size and shape of the bacterial cells were captured at various magnifications using the Hitachi S-3700N model [20].
Potent silicate solubilizing bacterial isolate was identified using 16S rRNA gene sequencing. Bacterial culture was inoculated into 100 mL of Luria Bertani liquid medium and kept on an orbital shaker for 12 h. As per the standard protocol, 16S rRNA gene was extracted and amplification was carried out using the universal primers 518 F- CCAGCAGCCGCGGTAATACG and 800 R - TACCAGGGTATCTAATCC. The polymerase chain reaction product was outsourced for Sanger’s sequencing [21]. Quality of the raw DNA sequences was checked using the Fast QC software, bad quality DNA sequences, and chimeric sequences were removed. Good quality 16S rRNA gene sequences obtained was aligned by Clustal W and a neighbor-joining tree was constructed using MEGA X software. The 16S rRNA gene sequence obtained was submitted to the NCBI GenBank database and an accession number was obtained [20,22].
3. RESULTS
3.1. Sample Collection and Isolation of the Potent Strain
Among all the pH indicator dyes (phenol red, bromocresol purple, and bromothymol blue) used, bromocresol purple (0.0025%) showed rapid and proper visualization of the clearance zones which was further used for the screening of silicate solubilizing isolates [Figure 1].
| Figure 1: Acid base dyes showing zone of silicate solubilization. [Click here to view] |
A total of seven isolates were obtained using a modified silicate solubilization plate assay. When compared to all the bacterial isolates, SKSSB09 showed a high and distinct yellow zone of silicate solubilization (7.5 ± 0.6 mm) within 72 h of incubation followed by SSB029 (5.7 ± 0.5 mm) [Figure 2].
 | Figure 2: Silicate solubilization zones of the bacterial isolates recorded after 72 h. [Click here to view] |
3.2. Silicate Solubilization Assay and Organic Acids Characterization
After 5 days of incubation, the samples were tested using the standard ammonium molybdate method which showed 546.23 ± 3.4 μg/mL of silicate solubilization in SKSSB09 followed by 428.91 ± 3.2 in SSB029 [Figure 3].
 | Figure 3: Graph showing the quantification of silicates solubilized by the silicate solubilizing bacterial isolates in μg/mL. [Click here to view] |
Bacterial culture filtrate of SKSSB09 was analyzed using GC-MS and the spectrum obtained was compared with the NIST database revealing the organic acids as propanoic acid, acetic acid, butanoic acid, and glycolic acid. The four organic acids secreted by the SKSSB09 showed a key role in the solubilization of magnesium trisilicate. The ion m/z chromatogram peaks 60.2511, 75.2675, 78.54, and 89.3659 represent propanoic acid, acetic acid, butanoic acid, and glycolic acid [Figure 4].
 | Figure 4: Ion m/z chromatogram showing peaks of acetic acid, propanoic acid, glycolic acid, and butanoic acid. [Click here to view] |
3.3. Qualitative and Quantitative Estimation of IAA
Among all the seven silicate solubilizing bacterial strains tested, SKSSB09 and SSB029 have tested positive by turning the solution to a pink color, indicating the presence of IAA. Whereas, the intensity of the pink color is high in SKSSB09 compared to the SSB029.
The culture supernatants of SKSSB09 and SSB029 were assessed by the calorimetric method. The absorbance values obtained at 530 nm were correlated with the standard graph and the amount of IAA produced by SKSSB09 was 61.2 ± 3.6 μg/mL and SSB029 was 48.6 ± 4.2 μg/mL.
3.4. Antagonistic Activity
F. oxysporum is a plant pathogen which causes huge economic losses all the world causing wilt in various crops which further leads to death of the plants. The in vitro antagonistic study on F. oxysporum showed 99% of mycelial inhibition when compared to the control in SKSSB09. Whereas, rest of the silicate solubilizing isolates showed no inhibition of F. oxysporum.
3.5. Morphological and Molecular Characterization of SKSSB09
Morphological study using scanning electron microscope revealed the silicate solubilizing SKSSB09 as rod shaped bacterium with blunt ends. The microbial isolate was identified by 16S rRNA gene sequencing studies and good quality DNA sequences obtained were searched in the NCBI BLAST database and were identified as Bacillus tequilensis with a sequence similarity of 99%. The partial 16S rRNA gene sequence was submitted to the NCBI Genbank database with the accession number (MW405905). Neighbor joining tree was constructed using MEGA X by taking Pseudomonas aeruginosa as an out group [Figure 5].
 | Figure 5: Neighbor-joining phylogenetic tree showing the evolution of Bacillus tequilensis SKSSB09 which was constructed with 1000 bootstrap replications. [Click here to view] |
4. DISCUSSION
Silica is the second most abundantly available mineral on the earth’s crust. Although several silica advantages are notified, the plants cannot directly utilize the complex silicates. In this scenario, microbes played a crucial role in the process of bio weathering and converting the insoluble silica into a soluble plant available form [23]. Accumulation of silica in the plants will provide tolerance to abiotic and biotic stress. Although several physicochemical reactions are involved in the dissolution of silica by microbes, some of the biochemical processes played a significant role in the mechanism of bio weathering [24].
Bio weathering by microbes is considered a crucial factor that releases the essential nutrients from the sediments and soil [2,17]. In the current research, a silicate solubilizing endospore-forming microbe was isolated from the rhizosphere soil of maize. The conventional Bunt and Rovira selective medium were widely used for the isolation of silicate solubilizing bacteria. Observation of silicate solubilizing zones in the conventional selective media is a bit challenging as the zones formed will be off-white and translucent.
Similar challenges were also faced in the Aleksandrov medium (potash solubilizers) and Pikovskaya medium (phosphate solubilizers) which are dependent on the acidolysis process. These challenges were rectified by the addition of acid base indicator dyes. Among all the acid base dyes tested, bromocresol purple showed good clearance zones followed by phenol red. Bromocresol purple reacted with the organic acids secreted by the bacterium and formed a distinct yellow zone in purple color media.
Silicate solubilization is also an acidolysis process, in which silicate solubilizing bacteria utilize glucose for the secretion of organic acids. Bromocresol purple was used as an acid base indicator dye in the qualitative analysis of silica and phosphate solubilization in the earlier reports [1]. Whereas, bromothymol blue was used in the rapid screening of potash solubilizing bacteria. The incorporation of bromothymol blue in the medium showed a significant correlation between the halo zones formed and the amount of potassium released in the liquid medium [12]. Based on the results obtained in the present study, bromocresol purple was selected as a suitable acid base dye for the modified plate assay.
The screening was done on the modified selective media incorporated with 0.0025% of bromocresol purple. The addition of bromocresol purple will ease the process of screening when compared to the conventional screening method. Among the seven isolates obtained, SKSSB09 isolate showed a higher silicate solubilization zone with distinct yellow color when incubated for 5 days. Organic acids secreted by the SKSSB09 reacted with the bromocresol purple dye forming yellow color zones around the bacterial culture [1].
In the earlier reports, various concentrations (0.00125%, 0.0025%, 0.005%, and 0.01%) of bromocresol purple were used in the silicate solubilization medium and the concentration optimization studies were carried out. A major focus was made on the optimization of concentration within a single acid base dye which can be effectively used for the qualitative and quantitative analysis of potash and silicate solubilizing bacteria [1]. In the present study, screening was carried out between three different acid base dyes, that is, bromothymol blue, bromocresol purple and phenol red.
Quantitative estimation of silicate solubilizing bacterial culture filtrate showed 546.23 ± 3.4 μg/mL of silicate solubilization. Results obtained are on par with the previous reports, 495.38 – 741.38 μg/mL of silicate solubilization when 0.125% of CaCl2 and MgNO3 were used in a selective medium [1]. Similar reports were recorded on Rhizobium spp. which showed silicate solubilization of 662 μg/mL [7]. Four types of organic acids, namely, propanoic acid, acetic acid, butanoic acid, and glycolic acid were detected from the culture filtrate extract of B. tequilensis SKSSB09.
Earlier reports showed the detection of gluconic acid, hydroxy propionic acid, tartaric acid, maleic acid, fumaric acid, acetic acid, and succinic acids [1,17]. Apart from acetic acid and propionic acid, the present study revealed the secretion of butanoic acid and glycolic acid for the 1st time. Various mechanisms were observed in the microbial silicate bio weathering process, which includes the formation of carbonic acid by the hydration of CO2 and the production of amino acids, phenolic compounds and organic acids by microbes that dissolute the silicates [25]. Organic acids secreted by the bacterium not only dissolute the silicates but also provide H+ for the hydrolysis of silicates. H+ ions act as chelating agents and form complexes with cationic materials [7,11,26].
Bacterial culture filtrate when tested with Salkowski’s reagent showed the presence of IAA. Production of IAA by B. tequilensis SKSSB09 was quantified using the calorimetric method which showed 61.2 ± 3.6 μg/mL. Similar results were also recorded by the previous researchers for Bacillus spp. which showed IAA production in the range of 14.4–92.7 μg/mL [27]. Research on the plant growth promoting Rhizobium sp. showed silicate solubilization efficiency and IAA secretion (0.95 ± 0.14 μg IAA/μg) [7].
IAA has several proven reports stating the promotion of plant growth in several ways which will be an add on benefit for the silicate solubilizing bacterial isolate SKSSB09. IAA enhances plant growth by cell elongation and improving cell multiplication. IAA also increases the root hairs and the rootlets. Recent research studies show IAA as a key signaling molecule in establishing the plant-microbe relationship [1,2,6].
Antagonistic activity of SKSSB09 against plant pathogen F. oxysporum showed 99% of mycelial inhibition. This reveals the antagonistic activity of silicate solubilizing bacteria by the secretion of HCN, siderophores, and hydrolytic enzymes [13,28]. In general, most plant beneficial microbes regulate several plant physiological activities, namely, secretion of secondary metabolites, stress mitigation, germination improvement, and cell division [2].
Scanning electron microscopic image revealed the structure of SKSSB09 as rod shape bacterium with blunt ends. 16S rRNA gene sequencing analysis was performed and the DNA sequence was compared with the DNA sequences in the NCBI BLAST database revealing the isolate SKSSB09 as B. tequilensis. Phylogenetic tree was constructed by taking Pseudomonas as an out group. Bacillus and Pseudomonas are very distantly related groups and taking Pseudomonas as an out group gives a proper phylogenetic tree. Bacillus is a gram positive, endospore-forming bacterium with a wide range of applicability in the production of enzymes, biocontrol efficacy, and secretion of antimicrobial compounds [29].
Morphology of B. tequilensis showed close resemblance with the Bacillus mucilaginosus which is widely used in studying the silicate-microbial interactions [26]. There are no prior reports stating B. tequilensis as a silicate solubilizer, but the present research revealed the efficiency of B. tequilensis as a potent silicate solubilizer for the 1st time and it can also be used as a plant beneficial microbial inoculant.
5. CONCLUSION
In the current global scenario, silica has an impeccable ability to provide tolerance towards the abiotic and biotic stress to plants. Silicate solubilizing B. tequilensis SKSSB09 has good silicate solubilization efficiency and remarkable ability to secrete organic acids. Apart from the silicate solubilization ability, SKSSB09 also secreted IAA which enhances the growth promotion in plants. Antagonistic activity against the F. oxysporum showed high mycelial inhibition revealing its utilization as a biocontrol agent. Based on the above research study, it can be concluded that B. tequilensis SKSSB09 can be effectively used as a silicate solubilizing bacterial inoculant in the maize crop.
6. ACKNOWLEDGMENTS
We would like to acknowledge VIT-SIF Lab, SAS, Chemistry Division for GC-MS analysis.
7. AUTHOR CONTRIBUTIONS
All authors made substantial contributions to conception and design, acquisition of data, or analysis and interpretation of data; took part in drafting the article or revising it critically for important intellectual content; agreed to submit to the current journal; gave final approval of the version to be published; and agreed to be accountable for all aspects of the work. All the authors are eligible to be an author as per the International Committee of Medical Journal Editors (ICMJE) requirements/guidelines.
8. FUNDING
This work was funded by Rashtriya Uchchatar Shiksha Abhiyan - Phase II (RUSA 2.0) -Biological sciences (TN RUSA: 311/RUSA (2.0)/2018 dt. December 2, 2020), Ministry of Human Resource and Development, India.
9. CONFLICT OF INTEREST
The authors report no financial or any other conflicts of interest in this work.
10. ETHICAL APPROVAL
The present research work does not contain any work related to the human or animal studies and does not require any ethical approval from the committee.
11. DATA AVAILABILITY
The datasets generated during and/or analyzed during the current study are available from the corresponding author on reasonable request.
12. PUBLISHER’S NOTE
This journal remains neutral with regard to jurisdictional claims in published institutional affiliation.
REFERENCES
1. Bist V, Niranjan A, Ranjan M, Lehri A, Seem K, Srivastava S. Silicon-solubilizing media and its implication for characterization of bacteria to mitigate biotic stress. Front Plant Sci 2020;11:28. [CrossRef]
2. Lee KE, Adhikari A, Kang SM, You YH, Joo GJ, Kim JH, et al. Isolation and characterization of the high silicate and phosphate solubilizing novel strain Enterobacter ludwigii GAK2 that promotes growth in rice plants. Agronomy 2019;9:144. [CrossRef]
3. Abdel Latef AA, Tran LS. Impacts of priming with silicon on the growth and tolerance of maize plants to alkaline stress. Front Plant Sci 2016;7:243. [CrossRef]
4. Fauteux F, Rémus-Borel W, Menzies JG, Bélanger RR. Silicon and plant disease resistance against pathogenic fungi. FEMS Microbiol Lett 2005;249:1-6. [CrossRef]
5. Shabbir I, Samad MY, Othman R, Wong MY, Sulaiman Z, Jaafar NM, et al. Silicate solubilizing bacteria UPMSSB7, a potential biocontrol agent against white root rot disease pathogen of rubber tree. J Rubber Res 2020;23:227-35. [CrossRef]
6. Kang SM, Waqas M, Shahzad R, You YH, Asaf S, Khan MA, et al. Isolation and characterization of a novel silicate-solubilizing bacterial strain Burkholderia eburnea CS4-2 that promotes growth of japonica rice (Oryza sativa L. cv. Dongjin). Soil Sci Plant Nutr 2017;63:233-41. [CrossRef]
7. Chandrakala C, Voleti SR, Bandeppa S, Kumar NS, Latha PC. Silicate solubilization and plant growth promoting potential of Rhizobium sp. Isolated from rice rhizosphere. Silicon 2019;11:2895-906. [CrossRef]
8. Zhao F, Qiu G, Huang Z, He L, Sheng X. Characterization of Rhizobium sp. Q32 isolated from weathered rocks and its role in silicate mineral weathering. Geomicrobiol J 2013;30:616-22. [CrossRef]
9. Liu W, Xu X, Wu X, Yang Q, Luo Y, Christie P. Decomposition of silicate minerals by Bacillus mucilaginosus in liquid culture. Environ Geochem Health 2006;28:133-40. [CrossRef]
10. Luyckx M, Hausman JF, Lutts S, Guerriero G. Silicon and plants:Current knowledge and technological perspectives. Front Plant Sci 2017;8:411. [CrossRef]
11. Bunt JS, Rovira AD. Microbiological studies of some subantarctic soils. J Soil Sci 1955;6:119-28. [CrossRef]
12. Rajawat MV, Singh S, Tyagi SP, Saxena AK. A modified plate assay for rapid screening of potassium-solubilizing bacteria. Pedosphere 2016;26:768-73. [CrossRef]
13. Naureen Z, Aqeel M, Hassan MN, Gilani SA, Bouqellah N, Mabood F, et al. Isolation and screening of silicate bacteria from various habitats for biological control of phytopathogenic fungi. Am J Plant Sci 2015;6:2850-9. [CrossRef]
14. Sulizah A, Rahayu YS, Dewi SK. Isolation and characterization of silicate-solubilizing bacteria from paddy rhizosphere (Oryza sativa L.). J Phys Conf Ser 2018;1108:012046. [CrossRef]
15. Raffi MM, Charyulu P. Nitrogen fixation by the native Azospirillum spp. Isolated from rhizosphere and non-rhizosphere of foxtail millet. Asian J Biol Life Sci 2012;1:213-8.
16. Elliot CL, Snyder GH. Autoclave induced digestion for the calorimetric determination of silicon in rice straw. J Agri Food Chem 1991;39:1118-9. [CrossRef]
17. Vasanthi N, Saleena LM, Raj SA. Silica solubilization potential of certain bacterial species in the presence of different silicate minerals. Silicon 2018;10:267-75. [CrossRef]
18. Akbari GA, Arab SM, Alikhani HA, Allahdadi I, Arzanesh MH. Isolation and selection of indigenous Azospirillum spp. And the IAA of superior strains effects on wheat roots. World J Agric Sci 2007;3:523-9.
19. Yunus FU, Iqbal M, Jabeen K, Kanwal Z, Rashid F. Antagonistic activityof Pseudomonas fluorescens against fungal plant pathogen Aspergillus niger. Sci Lett 2016;4:66-70.
20. Busi S, Karuganti S, Rajkumari J, Paramanandham P, Pattnaik S. Sludge settling and algal flocculating activity of Extracellular Polymeric Substance (EPS) derived from Bacillus cereus SK. Water Environ J 2017;31:97-104. [CrossRef]
21. Thajuddin N, Muralitharan G, Sundaramoorthy M, Ramamoorthy R, Ramachandran S, Akbarsha MA, et al. Morphological and genetic diversity of symbiotic cyanobacteria from cycads. J Basic Microbiol 2010;50:254-65. [CrossRef]
22. Li X, Sun P, Zhang Y, Jin C, Guan C. A novel PGPR strain Kocuria rhizophila Y1 enhances salt stress tolerance in maize by regulating phytohormone levels, nutrient acquisition, redox potential, ion homeostasis, photosynthetic capacity and stress-responsive genes expression. Environ Exp Bot 2020;174:104023. [CrossRef]
23. Santi LP, Haris N, Mulyanto D. Effect of bio-silica on drought tolerance in plants. IOP Conf Ser Earth Environ Sci 2018;183:012014. [CrossRef]
24. Bin L, Ye C, Lijun Z, Ruidong Y. Effect of microbial weathering on carbonate rocks. Earth Sci Front 2008;15:90-9. [CrossRef]
25. Sheng XF, Zhao F, He LY, Qiu G, Chen L. Isolation and characterization of silicate mineral-solubilizing Bacillus globisporus Q12 from the surfaces of weathered feldspar. Can J Microbiol 2008;54:1064-8. [CrossRef]
26. Mo B, Lian B. Interactions between Bacillus mucilaginosus and silicate minerals (weathered adamellite and feldspar):Weathering rate, products, and reaction mechanisms. Chin J Geo 2011;30:187-92. [CrossRef]
27. Ali B, Sabri AN, Ljung K, Hasnain S. Auxin production by plant associated bacteria:Impact on endogenous IAA content and growth of Triticum aestivum L. Lett Appl Microbiol 2009;48:542-7. [CrossRef]
28. Islam MA, Nain Z, Alam MK, Banu NA, Islam MR. In vitro study of biocontrol potential of rhizospheric Pseudomonas aeruginosa against Fusarium oxysporum f. sp. cucumerinum. Egypt J Biol Pest Cont 2018;28:90. [CrossRef]
29. Li H, Guan Y, Dong Y, Zhao L, Rong S, Chen W, et al. Isolation and evaluation of endophytic Bacillus tequilensis GYLH001 with potential application for biological control of Magnaporthe oryzae. PLoS One 2018;13:e0203505. [CrossRef]